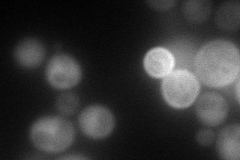
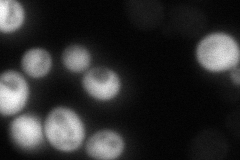
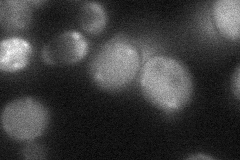
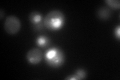

View description
Beta 1 subunit of the 20S proteasome, responsible for cleavage after acidic residues in peptides
Localization:
Intensity:
Fold change:
Significance:
-
C’ GFP library in SD

nucleus169.82 -
N' NOP1pr-GFP in SD
cytosol94.8991 -
N' TEF2pr-mCherry in SD

cytosol239.425 -
N' NATIVEpr-GFP in SD
below threshold19.1048 -
N' TEF2pr-VC and Cyto-VN in SD
cytosol,punctate34.4134 -
C’ GFP library in SD+DTT
nucleus105.540.62No -
C’ GFP library in SD+H2O2

nucleus246.71.45Yes -
C’ GFP library in Starvation Media

nucleus274.161.61Yes -
C’ GFP library on the background of Pup2-DaMP

nucleus -
C’ GFP library on the background of CCT mutant

nucleus91.37660.538062Yes
